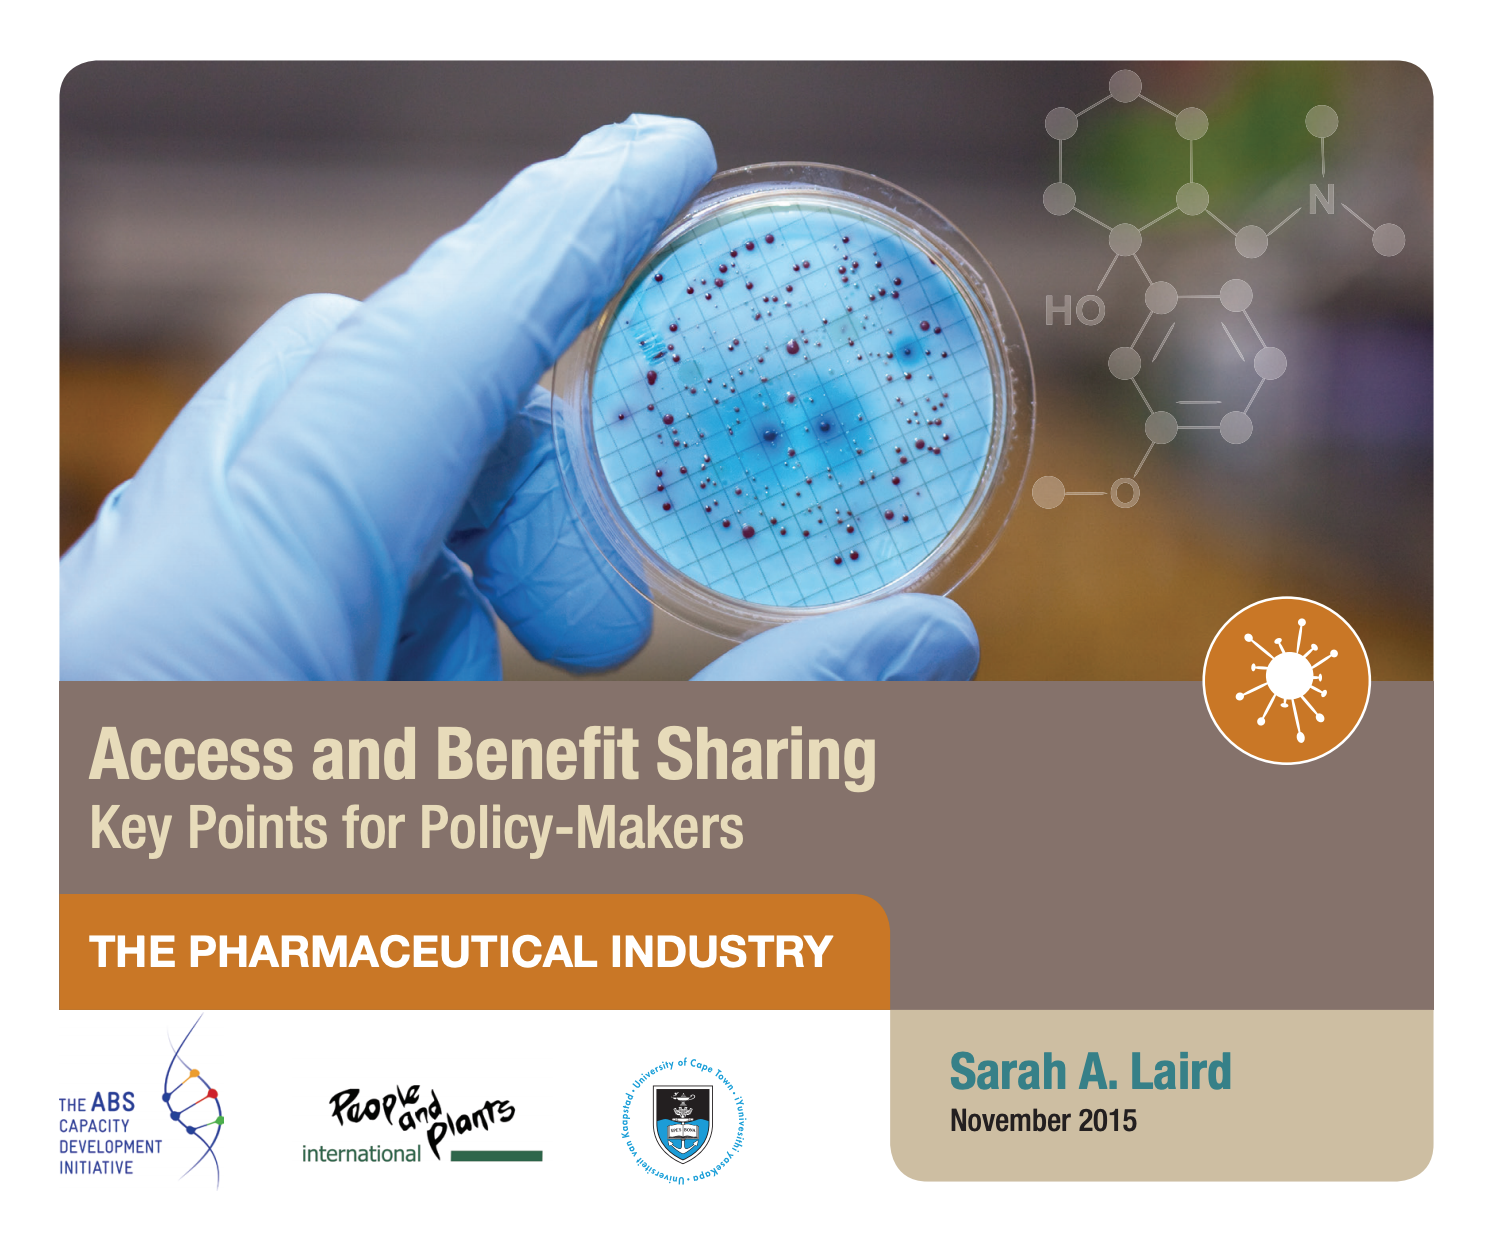

Voices for BioJustice
Wild populations of Agave marmorata in Zapotitlán Salinas, Mexico. (Photo: Ignacio Torres-García)
A large part of People and Plant’s work on Policy and Trade is undertaken today through the Voices for BioJustice Program. We created this program in 2017 in partnership with the University of Cape Town and other groups to facilitate global, multi-institutional collaboration on some of the most challenging biodiversity conservation and social justice policy issues of our time.
These include access and benefit sharing policies growing from the Convention on Biological Diversity and the Nagoya Protocol; challenges for equitable biodiversity conservation posed by rapid scientific advances and emerging technologies; and addressing negative consequences for biodiversity, and indigenous and rural communities, that can result from policies and laws, including sometimes conservation law.
Selected Resources
People and Plants collaborates with groups around the world to develop resources and tools for policy makers. These include policy briefs that distill technical or complex information into forms that are easily used by policy-makers and others, as well as those that communicate the knowledge and experiences of local groups on the margins of the policy process who are significantly impacted by laws and policies. We also produce research reports, fact-finding and scoping papers, and articles that reach a range of audiences and stakeholders.
Forests, trees and wild species in agrifood systems
FAO, People and Plants International, and the Alliance of Bioversity International and the International Center for Tropical Agriculture (CIAT) have released a policy brief. It is aimed at forest, agriculture and health practitioners, landscape and land-use planners and associated decision and policymakers. It reviews literature on the opportunities and challenges surrounding forest food and traditional food systems, focusing on three interrelated themes:
Nutrition, diversity and health
Sustainable and adaptive management systems
Equitable and sustainable value chains
The brief concludes with recommendations for policymakers, government institutions, private sector entities and practitioners to help them make informed decisions in support of healthy, biodiverse and climate-resilient agrifood systems.
Download PDF and learn more about the brief.
Click here to read an article about the brief on the FoodTank blog.
Connecting The Dots...
Biodiversity Conservation, Sustainable Use And Access And Benefit Sharing
People and Plants International, in partnership with Voices for BioJustice and the University of Cape Town, and supported by GIZ and BMZ, produced the report Connecting The Dots... Biodiversity Conservation, Sustainable Use And Access And Benefit Sharing. The research supporting this report included interviews with 85 individuals from governments, research institutions, NGOs and the private sector, in the four BioInnovation Africa countries of Cameroon, Madagascar, Namibia and South Africa, and also globally.
Click here to download the Report. The Executive Summary is available in English and French.
Exploring the Scope of Access and Benefit Sharing Measures
Implications for Implementation in the COMIFAC Region
Voices for BioJustice a collaboration between People and Plants, the University of Cape Town, the Swift Foundation and others, held a webinar in July 2020 as part of the webinars series Benefit sharing and traditional knowledge: unsolved dilemmas for implementation. Learn more
BRINGING THE VOICES OF INDIGENOUS PEOPLES
AND LOCAL COMMUNITIES INTO GLOBAL ARENAS
Voices for BioJustice a collaboration between People and Plants, the University of Cape Town, the Swift Foundation and others, held a webinar in June 2020 as part of the webinars series Benefit sharing and traditional knowledge: unsolved dilemmas for implementation. Learn more
THE CHALLENGE OF ATTRIBUTION AND ORIGIN
TRADITIONAL KNOWLEDGE AND ACCESS AND BENEFIT SHARING
Voices for BioJustice a collaboration between People and Plants, the University of Cape Town, the Swift Foundation and others, held a webinar in June 2020 as part of the webinars series Benefit sharing and traditional knowledge: unsolved dilemmas for implementation. Learn more
WHAT ARE WE REGULATING?
The scope of access and benefit sharing
Voices for BioJustice held a webinar in March 2020 to explore issues of scope relating to ABS. A policy brief and background videos were also produced in support of this process.
People and Plants (2023) Viewpoint on priorities for progress towards Sustainable Development Goal 15 'Life on land'. Nature, Ecology and Evolution.
Download PDF.
Sarah Laird, Rachel Wynberg, Michelle Rourke, Fran Humphries, Manuel Ruiz Muller and Charles Lawson (2020). Rethink the expansion of access and benefit sharing. Science 367(6483).
Download PDF.
Sarah Laird, Anne L.S. Virnig and Rachel Wynberg. (2018). Access And Benefit-Sharing Agreements: Resources And Background Materials. Voices for Biojustice; University of Cape Town; The Darwin Initiative; People and Plants International; The ABS Capacity Development Initiative; The Christensen Fund.
A group of collaborators created this resource packet to provide case studies, sample documents, and background on ABS Agreements. These include commercial and research agreements; institutional, industry and protected area ABS policies; codes of ethics and research guidelines; indigenous peoples' declarations, guidelines and statements; and links to resources compiled by other groups working on these and related issues. Work is underway around the world on ABS arrangements, and this document is intended as a starting point from which we will build the collection through crowd-sourcing.
Download PDF.
Sarah Laird and Rachel Wynberg. (2017). Access and Benefit Sharing in a Time of Scientific, Technological and Market Change Essential Lessons for Policy-Makers. University of Cape Town; People and Plants International; The ABS Capacity Development Initiative.
The ‘Essential Lessons’ gathered here are the fruits of many years’ work on emerging technologies, the commercial use of genetic and biological resources, and engagement in ABS policy processes. The lessons are presented simply, with visual images and minimal explanatory text.
Download PDF.
Sarah Laird and Rachel Wynberg. (2015). Access and Benefit Sharing: Key Points for Policy-Makers. The ABS Capacity Development Initiative; GIZ; University of Cape Town; and People and Plants International.
A series of policy briefs were produced in November 2015 by the GIZ’s ABS Capacity Development Initiative, People and Plants International, and the University of Cape Town. Through infographics and accessible text, the briefs communicate key points for policy-makers seeking to develop and implement effective ABS (access and benefit-sharing) measures. Trends in markets, research, and law are highlighted for a range of sectors.
Sarah Laird and Rachel Wynberg. (2013). Bioscience at a Crossroads: Access and Benefit Sharing in a Time of Scientific, Technological and Industry Change. Secretariat of the Convention on Biological Diversity.
In 2013, the Secretariat of the Convention on Biological Diversity published a series of policy briefs and fact sheets, Bioscience at a Crossroads: Access and Benefit Sharing in a Time of Scientific, Technological and Industry Change. These documents make policy recommendations for Nagoya Protocol implementation and review and analyze recent scientific, technological, market and legal developments in six industries.
Laird, S. and Wynberg, R. (2022) Access and Benefit Sharing and Biodiversity Conservation. In: Access and Benefit Sharing of Genetic Resources, Information and Traditional Knowledge. Routledge. Download PDF.
Humphries, F., Laird, S., Wynberg, R., Morrison, C. Lawson, C. and Kolesnikova, A. (2021). Survey of access and benefit-sharingcountry measures accommodating the distinctive features of genetic resources for food and agriculture and associatedtraditional knowledge. Rome, FAO on behalf of the Commission on Genetic Resources for Food and Agriculture. Download PDF.
Wynberg, R., Andersen, R., Laird, S., Kusena, K., Prip, C .and Westengen, O.T. (2021) Farmers’ Rights and Digital Sequence Information: Crisis or Opportunity to Reclaim Stewardship Over Agrobiodiversity? Front. Plant Sci. 12:686728. Download PDF.
Sarah A. Laird and Rachel P. Wynberg, with contributions from Arash Iranzadeh and Anna Sliva Kooser. (2018). A Fact-Finding and Scoping Study on Digital Sequence Information on Genetic Resources in the Context of the Convention on Biological Diversity and the Nagoya Protocol. Convention on Biological Diversity.
Download PDF.Sarah A. Laird and Rachel P. Wynberg. (2018). Fast Science and Sluggish Policy: The Herculean Task of Regulating Biodiscovery. Trends in Biotechnology 36(1).
Download PDF.Sarah A. Laird and Rachel P. Wynberg. (2016). Locating Responsible Research and Innovation Within Access and Benefit Sharing Spaces of the Convention on Biological Diversity: the Challenge of Emerging Technologies. Nanoethics 10.
Download PDF.Sarah A. Laird and Rachel P. Wynberg. (2012). Diversity and Change in the Commercial Use of Genetic Resources: Implications for Access and Benefit Sharing Policy. International Journal of Ecological Economics & Statistics 26(3).
Download PDF.
Partners